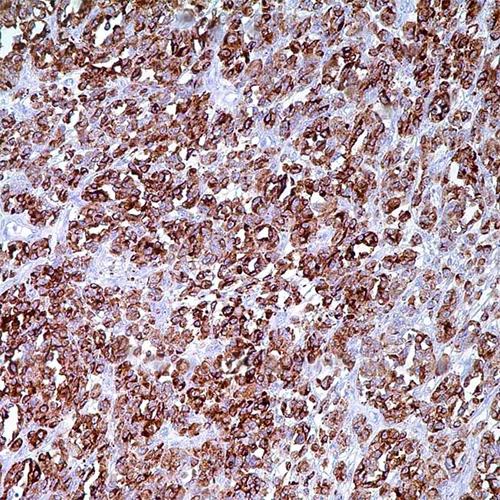

| Clone | Clone PNL2 |
|---|---|
| REF | PSV-IHI0382 |
| Dilution | 1:50 |
| Staining | Cytoplasmic |
| Control tissue | Normal skin or melanoma tissue section |
| Isotype | IgG1 |
| Species of origin | Mouse |
Intended use:
This antibody is intended for in vitro diagnostic (IVD) use. Primary Antibody is intended for professional laboratory use in formalin-fixed, paraffin-embedded (FFPE) tissue stained in manual qualitative immunohistochemistry (IHC) testing. A qualified pathologist must interpret the results using this product to aid diagnosis in conjunction with the patient’s relevant clinical history, other diagnostic tests, and proper controls.
Presentation:
Anti-human PNL2 mouse monoclonal antibody purified from serum and prepared in 10mM PBS, pH 7.4, with 0.2% BSA and 0.09% sodium azide